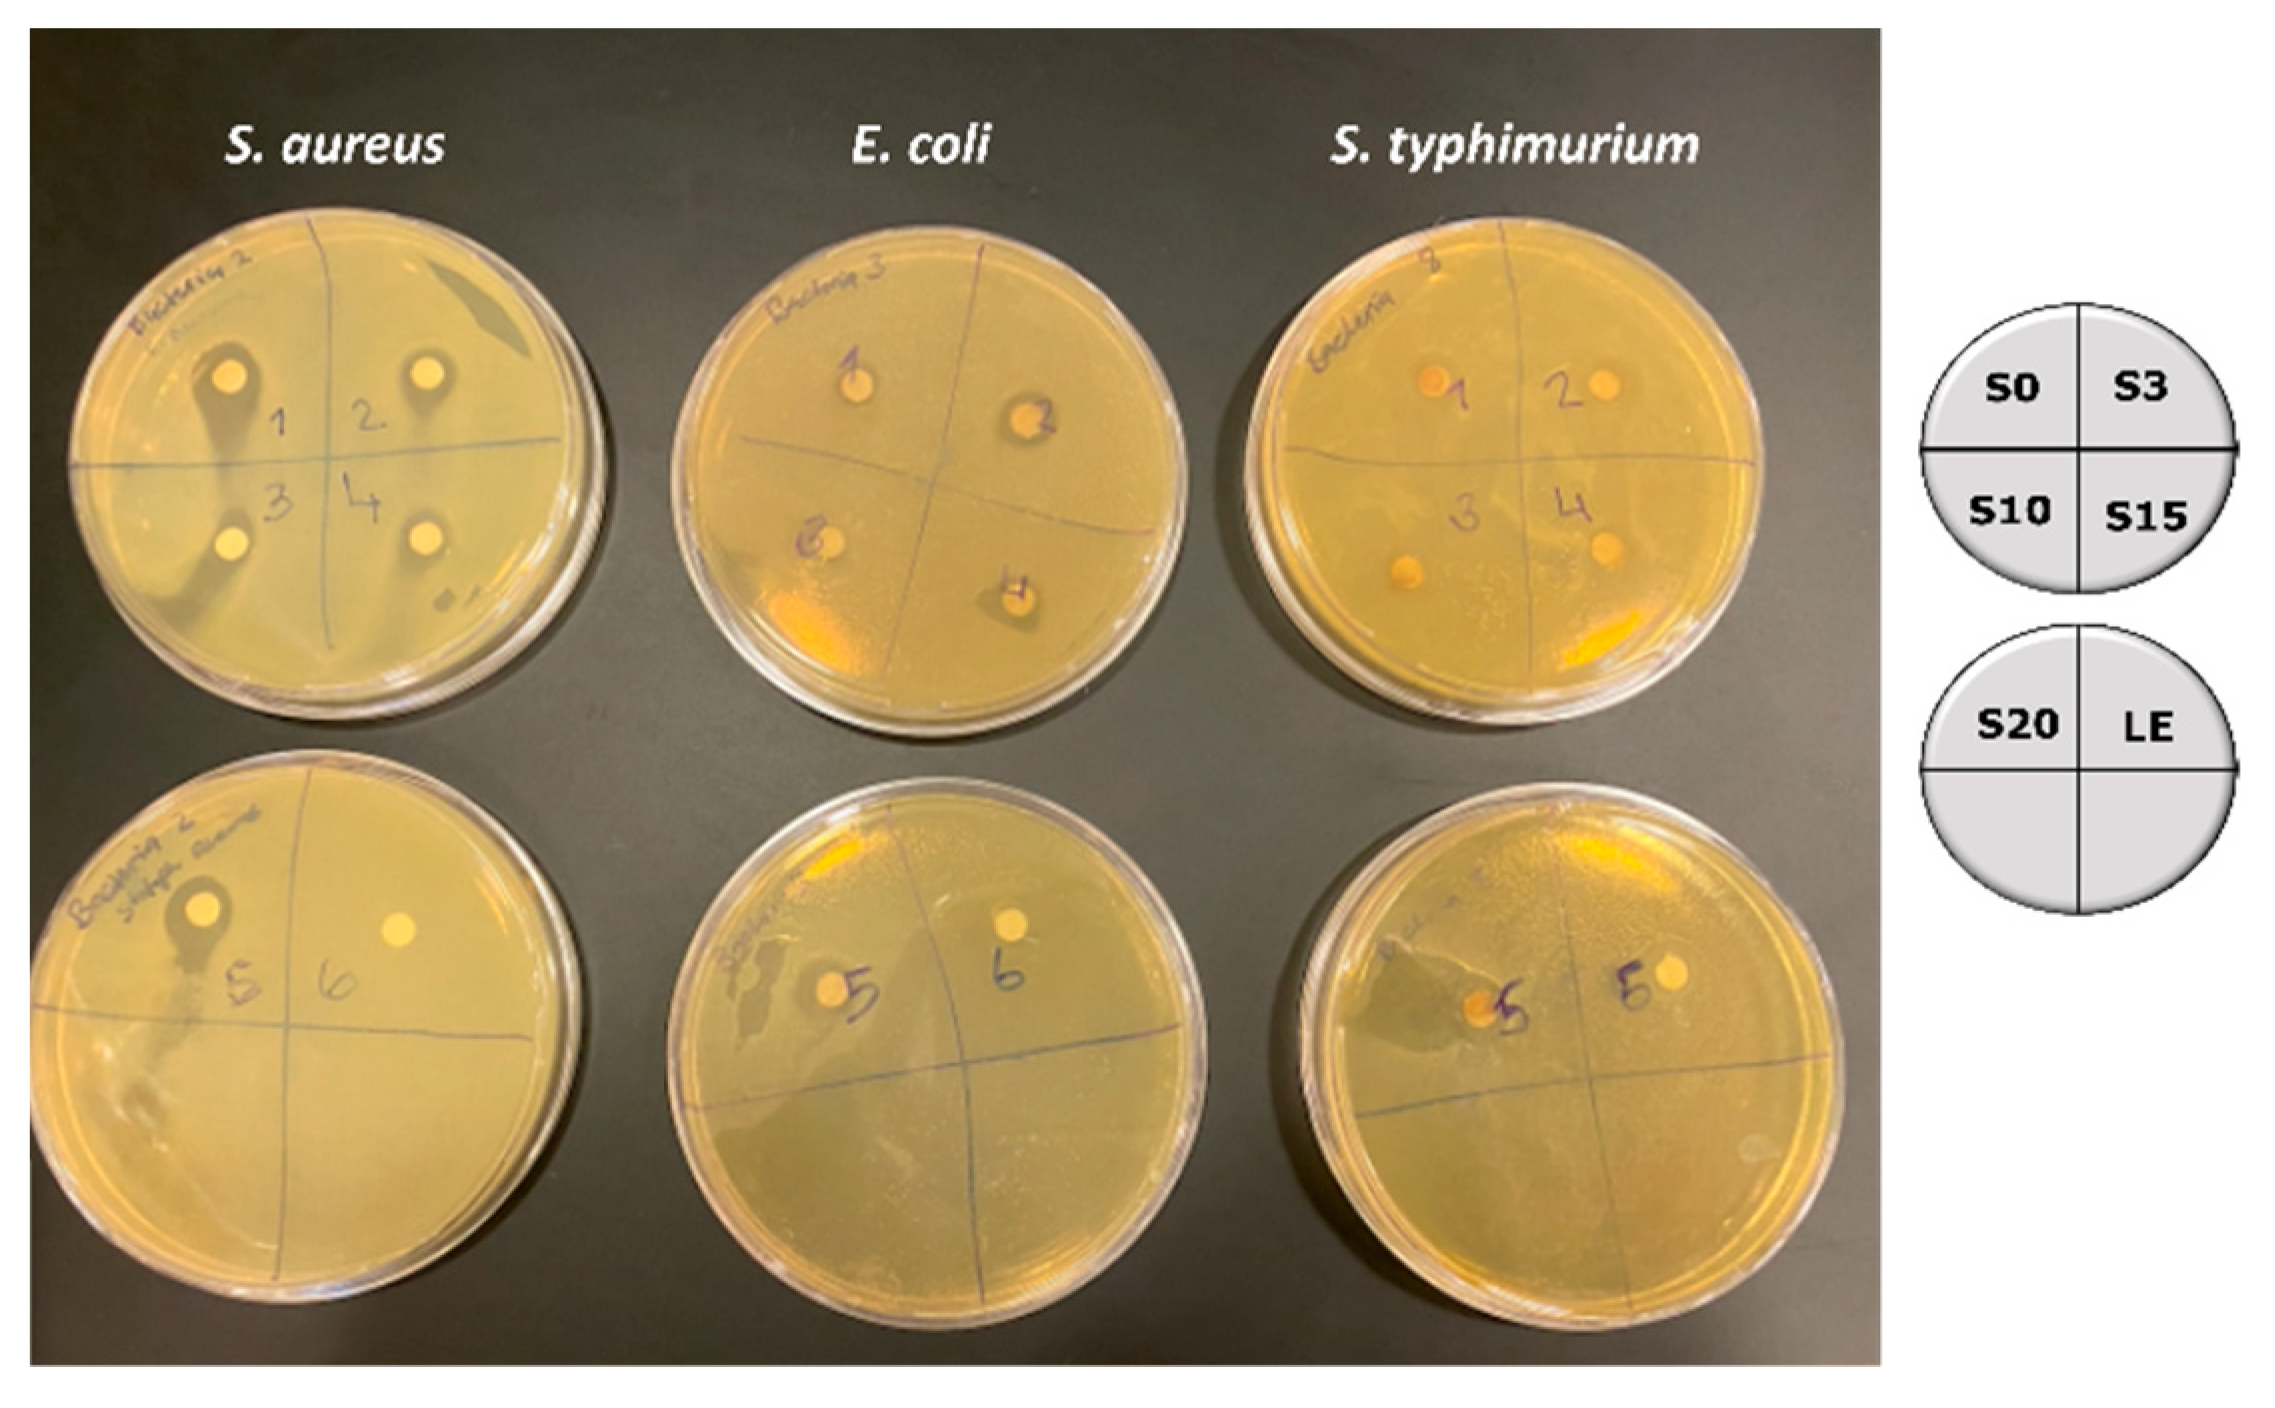

Effects of Different Parts of the Okra Plant (Abelmoschus esculentus) on the Phytosynthesis of Silver Nanoparticles: Evaluation of Synthesis Conditions, Nonlinear Optical and Antibacterial Properties
Abstract
1. Introduction
2. Materials and Methods
2.1. Materials
2.2. Preparation of Plant Extract and Synthesis of Silver Nanoparticles
2.3. UV-Vis Spectroscopy
2.4. Transmission Electron Microscopy (TEM)
2.5. Fourier Transform Infrared (FTIR) Spectroscopy
2.6. Energy-Dispersive X-ray Spectroscopy (EDX)
2.7. Nonlinear Optical Studies
2.8. Antibacterial Activity
3. Results
3.1. Formation of Silver Nanoparticles by In Situ Reduction Using Extracts of the Leaves, Stems, and Mature Pods of A. esculentus(okra)
3.2. Average Number of Silver Atoms per Nanoparticle and Molar Concentration
3.3. Functional Group Analysis
3.4. Morphology and Size of Silver Nanoparticles
3.5. Nonlinear Optical Property of Silver Nanoparticles
3.6. Antibacterial Property of Silver Nanoparticles
4. Conclusions
Author Contributions
Funding
Data Availability Statement
Acknowledgments
Conflicts of Interest
References
- Zhang, D.; Ma, X.; Gu, Y.; Huang, H.; Zhang, G. Green synthesis of metallic nanoparticles and their potential applications to treat cancer. Front. Chem. 2020, 8, 799–816. [Google Scholar] [CrossRef] [PubMed]
- Thakkar, K.; Mhatre, S.; Parikh, R. Biological synthesis of metallic nanoparticles. Nanotechnol. Biol. Med. 2009, 6, 257–262. [Google Scholar] [CrossRef] [PubMed]
- Roh, Y.; Lauf, R.J.; McMillan, A.D.; Zhang, C.; Rawn, C.J.; Bai, J.; Phelps, T.J. Microbial synthesis and the characterization of metal-substituted magnetite. Solid State Commun. 2001, 118, 529–534. [Google Scholar] [CrossRef]
- Narayanan, K.; Sakthivel, N. Green synthesis of biogenic metal nanoparticles by terrestrial and aquatic phototrophic and heterotrophic eukaryotes and biocompatible agents. Adv. Colloid Interface Sci. 2011, 169, 59–79. [Google Scholar] [CrossRef]
- Pantidos, N.; Horsfall, I.E. Biological synthesis of metallic nanoparticles by bacteria, fungi, and plants. J. Nanomed. Nanotechnol. 2014, 5, 233–240. [Google Scholar] [CrossRef]
- Iravani, S.; Zolfaghari, B. Green synthesis of silver nanoparticles using pinus eldarica bark extract. Biomed. Res. Int. 2013, 13, 639725–639731. [Google Scholar]
- Philip, D. Green synthesis of gold and silver nanoparticles using Hibiscus rosa sinensus. Phys. E Low Dimens. Syst. Nanostruct. 2010, 42, 1417–1424. [Google Scholar] [CrossRef]
- Sneha, K.; Sathish Kumar, M.; Lee, S.Y.; Bae, M.A.; Sun, Y.-S. Biosynthesis of Au Nanoparticles using cumin seed powder extract. J. Nanosci. Nanotech. 2011, 11, 1811–1814. [Google Scholar] [CrossRef]
- Huang, J.; Li, Q.; Sun, D.; Lu, Y.; Su, Y.; Yang, X.; Chen, C. Biosynthesis of silver and gold nanoparticles by novel sun dried Cinnamonum camphora leaf. Nanotechnology 2007, 18, 105104–105110. [Google Scholar] [CrossRef]
- Jia, L.; Zhang, Q.; Li, Q.; Song, H. The biosynthesis of palladium nanoparticles by antioxidants in Gardenia jasminoides: Long lifetime nanocatalysts for p-nitrotoluene hydrogenation. Nanotechnology 2009, 20, 385601–385611. [Google Scholar] [CrossRef]
- Kahzad, N.; Salehzadeh, A. Green synthesis of CuFe2O4@Ag nanocomposite using the chlorella vulgaris and evaluation of its effect on the expression of norA efflux pump gene among Staphylococcus aureus strains. Biol. Trace Elem. Res. 2020, 2011, 02050–02055. [Google Scholar] [CrossRef] [PubMed]
- Khatami, M.; Alijani, H.Q.; Nejad, M.S.; Varma, R.S. Core@shell nanoparticles: Greener synthesis using natural plant products. App. Sci. 2018, 8, 411. [Google Scholar] [CrossRef]
- Jayaseelan, C.; Ramkumar, R.; Abdul Rahman, A.; Perumal, P. Green synthesis of gold nanoparticles using seed aqueous extract of Abelmoschus esculentus and its antifungal activity. Ind. Crops Prod. 2013, 45, 423–429. [Google Scholar] [CrossRef]
- Mollick, M.R.; Bhowmick, B.; Mondal, E. Anticancer (in vitro) and antimicrobial effect of gold nanoparticles synthesized using Abelmoschus esculentus pulp extract via a green route. RSC Adv. 2014, 4, 37838–37848. [Google Scholar] [CrossRef]
- Lengsfeld, C.; Faller, G.; Hensel, A. Okra polysaccharide inhibit adhesion of Camplylobacter jejunito mucosa isolated from poultry in vitro but no in vivo. Anim. Feed Sci. Technol. 2007, 135, 113–125. [Google Scholar] [CrossRef]
- Sabouri, Z.; Akbari, A.; Ali, H.H.; Hashemzadeh, A.; Darroudi, M. Ecofriendly biosynthesis of nickel oxide nanoparticles mediated by okra plant extract and investigation of their photocatalytic, magnetic, cytotoxicity, and antibacterial properties. J. Clust. Sci. 2019, 30, 1425–1434. [Google Scholar] [CrossRef]
- Gu, L.; Hong, F.; Fan, K. Integrated network pharmacology analysis and pharmacological evaluation to explore the active components and mechanism of Abelmoschus Manihot on renal fibrosis. Drug Des. Dev. Ther. 2020, 14, 4053–4067. [Google Scholar] [CrossRef]
- Devanesan, S.; AlSahli, M.S. Green synthesis of silver nanoparticles using the flower extract of Abelmoschus esculentus for cytotoxicity and antimicrobial studies. Int. J. Nanomed. 2021, 16, 3343–3356. [Google Scholar] [CrossRef]
- Roddu, A.K.; Wahab, A.W.; Ahmad, A.; Taba, P. Microstructural analysis of silver nanoparticles resulted through bio-reduction using Abelmoschus esculentus leaf extract. J. Phys. Conf. Ser. 2019, 1341, 032002–032015. [Google Scholar] [CrossRef]
- Roddu, A.K.; Wahab, A.W.; Ahmad, A.; Taba, P. Green-route synthesis and characterization of the silver nanoparticles resulted by bio-reduction process. J. Phys. Conf. Ser. 2019, 1341, 032004–032018. [Google Scholar] [CrossRef]
- Sheik-Bahae, M.; Said, A.A.; Wei, T.-H.; Hagan, D.J.; Van Stryland, E.W. Sensitive measurement of optical nonlinearities using a single beam. IEEE J. Quantum Electron. 1990, 26, 760–769. [Google Scholar] [CrossRef]
- Selvaraj, V.; Sagadevan, S.; Muthukrishnan, L.; Johan, M.R.; Podder, J. Eco-friendly approach in synthesis of silver nanoparticles and evaluation of optical, surface morphological and antimicrobial properties. J. Nanostruct. Chem. 2019, 9, 153–162. [Google Scholar] [CrossRef]
- Mohanta, Y.K.; Biswas, K.; Jena, S.K.; Hashem, A.; Abd Allah, E.F.; Monata, T.K. Anti-biofilm and antibacterial activities of silver nanoparticles synthesized by the reducing activity of phytoconstituents present in the Indian medicinal plants. Front. Microbiol. 2020, 11, 1143–1156. [Google Scholar] [CrossRef]
- Elkhalifa, A.E.O.; Alshammari, E.; Adnan, M.; Alcantara, J.C.; Awadelkareem, A.M.; Eltoum, N.E.; Ashraf, S.A. Okra (Abelmoschus esculentus) as a potential dietary medicine with nutraceutical importance for sustainable health applications. Molecules 2021, 26, 696. [Google Scholar] [CrossRef] [PubMed]
- Noori Jassim, A.M.; Farhan, A.A.; Dadoosh, R.M. Green synthesis of silver nanoparticles using seed aqueous extract of Abelmoschus esculentus and study of their properties. Adv. Environ. Biol. 2016, 10, 51–66. [Google Scholar]
- Kalishwaralal, K.; Barath Manikanth, S.; Pandian, S.R.K.; Deepak, V.; Gurunathan, S. Silver nanoparticles impede the biofilm formation by Pseudomonas aeruginosa and Staphylococcus epidermis. Colloids Surf. B Biointerfaces 2010, 79, 340–344. [Google Scholar] [CrossRef]
- Abkhalimov, E.; Ershov, V.; Ershov, B. Determination of the concentration of silver atoms in hydrosol nanoparticles. Nanomaterials 2022, 12, 3091. [Google Scholar] [CrossRef]
- Mickymaray, S. One-step synthesis of silver nanoparticles using Saudi Arabian desert seasonal plant Sisymbrium irio and antibacterial activity against multi-drug resistant bacterial strain. Biomolecules 2019, 9, 662. [Google Scholar] [CrossRef]
- Jacinto, C.; Messias, D.N.; Andrade, A.A.; Lima, S.M.; Baesso, M.L.; Catunda, T. Thermal lens and z-scan measurements: Thermal and optical properties of laser glasses-a review. J. Non-Crystall. Solids 2006, 352, 3582–3597. [Google Scholar] [CrossRef]
- Philip, R.; Chantharasupawong, P.; Qian, H.; Jin, R.; Thomas, J. Evolution of non-linear optical properties: From gold atomic clusters to plasmonic nanocrystals. Nano Lett. 2012, 12, 4661–4667. [Google Scholar] [CrossRef]
- Abdulwahab, F.; Henari, F.Z.; Cassidy, S.; Winser, K. Synthesis of Au, Ag, curcumin Au/Ag and Au/Ag nanoparticles and their nonlinear refractive index properties. J. Nanomater. 2016, 2016, 5356404. [Google Scholar] [CrossRef]
- Naseer, M.; Aslam, U.; Khalid, B.; Chen, B. Green route to synthesize zinc oxide nanoparticles using leaf extracts of Cassia fistula and Melia azedarach and their antibacterial potential. Sci. Rep. 2020, 10, 9055. [Google Scholar] [CrossRef] [PubMed]
- Cittrarasu, V.; Kaliannan, D.; Dharman, K.; Maluventhen, V.; Easwaran, M.; Liu, W.C.; Balasubramanian, B.; Arumugam, M. Green synthesis of selenium nanoparticles mediated from Ceropegia bulbosa Roxb extract and its cytotoxicity, antimicrobial, mosquitocidal and photocatalytic activities. Sci. Rep. 2021, 11, 1032. [Google Scholar] [CrossRef] [PubMed]
- Yorseng, K.; Sieng Chin, S.; Ashok, I.B.; Rajulu, A.V. Nanocomposite egg shell powder with in-situ generated silver nanoparticles using inherent collagen as reducing agent. J. Biosour. Bioprod. 2020, 5, 101–107. [Google Scholar] [CrossRef]

| Wavelength, λ (nm) | α (cm−1) | n2 (×10−8) (cm2 W−1) | β (×10−6) (m W−1) |
|---|---|---|---|
| 488 | 3.46 | 3.65 | 2.80 |
| 514 | 3.18 | 2.93 | 2.27 |
Publisher’s Note: MDPI stays neutral with regard to jurisdictional claims in published maps and institutional affiliations. |
© 2022 by the authors. Licensee MDPI, Basel, Switzerland. This article is an open access article distributed under the terms and conditions of the Creative Commons Attribution (CC BY) license (https://creativecommons.org/licenses/by/4.0/).
Share and Cite
Deen, G.R.; Hannan, F.A.; Henari, F.; Akhtar, S. Effects of Different Parts of the Okra Plant (Abelmoschus esculentus) on the Phytosynthesis of Silver Nanoparticles: Evaluation of Synthesis Conditions, Nonlinear Optical and Antibacterial Properties. Nanomaterials 2022, 12, 4174. https://doi.org/10.3390/nano12234174
Deen GR, Hannan FA, Henari F, Akhtar S. Effects of Different Parts of the Okra Plant (Abelmoschus esculentus) on the Phytosynthesis of Silver Nanoparticles: Evaluation of Synthesis Conditions, Nonlinear Optical and Antibacterial Properties. Nanomaterials. 2022; 12(23):4174. https://doi.org/10.3390/nano12234174
Chicago/Turabian StyleDeen, G. Roshan, Fatima Al Hannan, Fryad Henari, and Sultan Akhtar. 2022. "Effects of Different Parts of the Okra Plant (Abelmoschus esculentus) on the Phytosynthesis of Silver Nanoparticles: Evaluation of Synthesis Conditions, Nonlinear Optical and Antibacterial Properties" Nanomaterials 12, no. 23: 4174. https://doi.org/10.3390/nano12234174
APA StyleDeen, G. R., Hannan, F. A., Henari, F., & Akhtar, S. (2022). Effects of Different Parts of the Okra Plant (Abelmoschus esculentus) on the Phytosynthesis of Silver Nanoparticles: Evaluation of Synthesis Conditions, Nonlinear Optical and Antibacterial Properties. Nanomaterials, 12(23), 4174. https://doi.org/10.3390/nano12234174

